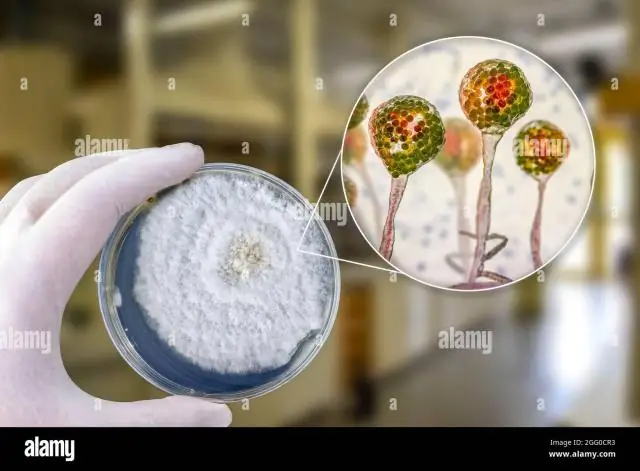

Черная плесень не мочь расти на бетоне. Это растет почти на всех органических материалах, особенно содержащих целлюлозу, таких как дерево, обои, гипсокартон, ковролин, клеи, ткань и хлопковая изоляция. Любое слабое обесцвечивание, независимо от цвета, может указывать на серьезное форма проблема.
Также нужно знать, что убивает черную плесень на бетоне?
- Поместите шланг на самый мощный рычаг, чтобы очистить бетон.
- Соскребите оставшуюся черную плесень с помощью шпателя.
- Смешайте раствор хлорного отбеливателя, моющего средства и воды.
- Нанесите раствор на бетон губкой или кистью.
- Смойте бетон.
- Потрите бетон и снова промойте, если черная плесень не исчезнет.
Кроме того, как выглядит плесень на бетоне? Цветение можно посмотреть очень похож на белый форма рост. Это происходит при прохождении влаги конкретный (или другие виды кладки) и увлекает минералы вместе с водой. Если нет, скорее всего форма растет в вашем подвале. Выглядит нравиться белый форма, но это всего лишь месторождения полезных ископаемых.
Просто так, опасна ли плесень на бетоне?
Опасности. Форма Споры могут вызывать множество видов риска для здоровья, особенно для тех, кто подвержен аллергии и респираторным заболеваниям (например, астма), а также могут вызывать воспалительную сыпь, головные боли и другие симптомы гриппа. Так что всякий раз, когда ты рядом бетонная форма, обязательно примите надлежащие меры предосторожности.
Как предотвратить рост плесени на бетоне?
Держите вашу бетонную форму свободной
- Вам понадобиться:
- Удалите плесень:
- Шаг 1: Наденьте старую или уже испачканную одежду и резиновые перчатки.
- Шаг 2: Добавьте 1 часть отбеливателя к 4 частям воды и тщательно перемешайте.
- Шаг 3: Окуните кисть в очиститель и тщательно потрите заплесневелые поверхности.
- Шаг 4: Дайте области высохнуть.
- Дополнительные советы: